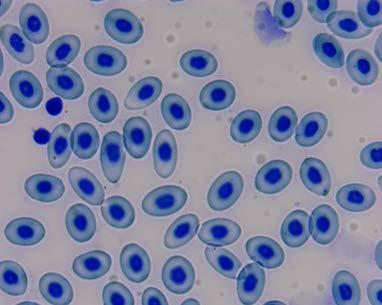

![]()











NÅ 1824,Spar 25%

Mikroskop SFC-100fl med okularkamera 3 MP
Nå har vi laget en pakke som inkluderer et basis mikroskop SFC100 fl,brukt i skolen i mange tiår, med et 3 MP okularkamera og programvare.
Kameraet kan brukes med andre mikroskoper og stereoluper.
Inkludert:
• Okularkamera med 23,2 diameter (Varenr.: 310221)
Mikroskop 100 FL (Varnr.: 307001)
Varenr.: Pris 310216 2445,-

NÅ 760,Spar 20% NÅ 968,Spar 25%
Okularokamera USB 3 MP
Inkludert:
Okularkamera med 23,2 diameter
2 stk adaptere (Ø30mm og Ø30.5mm)
• 1 USB-kabel kan koble til PC
Programvare (Image View)

Okularokamera USB 5 MP
Inkludert:
Okularkamera med 23,2 diameter
• 2 stk adaptere (Ø30mm og Ø30.5mm)
• 1 USB-kabel kan koble til PC
Programvare (Image View)



Mikroskopkamera HDMI/USB 5 MP inkl.adapter
Nytt mikroskopkamera hvor du kan koble direkte til HDMI (kabel inkludert) og få bilde i høyeste kvalitet på storskjerm uten programvare! I tillegg kan du bruke USB utgang (kabel inkludert) og ved hjelp av programvare se bildet på skjerm, ta bilde eller video og sende som filer for bruk i presentasjoner, rapporter eller sosiale media.
Programvaren har mange redigeringsmuligheter og filene kan også lagres på SD kort for bruk i andre applikasjoner.
Inkludert:
1 x Kamera
1 x Strømkilde
• 1 x USB-mus
1 x HDMI-kabel
1 x USB-kabel med programvare
• 1 x SD-kort (8G)
1 x Adapter med finfokuering
NÅ 4868,-
25%


Moticam A5 for USB
Moticam A5 er et 5 MP kamera som gir deg gode bilder og video med 30 bps og full HD oppløsning. Kobles til PC/Mac med USB2 kabel. Alle kamera leveres med «Alt-i-en-boks»: to okular adaptere for montering på okularet, en fokusérbar linse, en makro¬tubus for enkelt lupeoppsett, kalibreringspreparat, C-ring og USB-kabel. Programvaren MotiConnect for Windows/ Mac/Linux lastes gratis.
Spesifikasjoner:
Stillbilde: 5MB
• Video: 30bps, full HD Alt i en boks: JA
Programvare: MotiConnect for Windows/Mac/Linux

Varenr.: Pris
310196 3950,-
3160,-

Et kamera som gir deg et skarpt bilde med mange detaljer og god fargegjengivelse uten at du behøver programvare!
Digital kameralupe WiFi, 5 MP
Digital trådløs (wifi) kameralupe på stativ. Kan brukes kablet (kabel inkludert) eller trådløst og passer perfekt med Ipad. Studer plantedeler, insekter eller andre detaljer i regulerbart LED lys og med stor forstørrelse. Ta opp video eller ta bilder, programvare er inkludert.
Spesifikasjoner:
Forstørrelse: 10x – 230 x Batteri: Oppladbart Li-ion batteri
307102 2371,NÅ 1660,-

Motic leverer mikroskoper både til skoler og laboratorier. Dette er to klassiske mikroskoper for videregående skole. Optisk og mekanisk i toppklassen og med mange nye fine detaljer. For full beskrivelse og produktdetaljer se vår hjemmeside.

307148 6200,-

NÅ

307147 7400,-

Spesifikasjoner:
Hode 1 B: Binokulært (30° vinklet), 360° roterbart, Sidentopf
• Hode 1 T: Trinokulært (30° vinklet), 360° roterbart, Sidentopf. Inkludert 0,5x C-adapter for kameratilkobling
Okularavstand: 48 – 75 mm, +/- 5 mm diopter på venstre okular
• Okularer: 10x ekstra vidvinkel (WF10x/18mm) i par.
Objektivrevolver: Firedelt revolver.
• Objektiver: akromatiske (4x/0.10, 10x/0.25, 40x/N.A. 0.65/S, 100x/N.A. 0.85/S).
Forstørrelser: 40x, 100x, 400x og 1000x
Kondensor: Abbé-kondensor (N.A. 1.25) med filterholder. Justérbar i høyden. Blender: irisblender (fargekodet)for trinnløs regulering av lysstyrke, kontrast og dybdeskarphet.
Belysning: LED (1 W)) med trinnløs regulering.
• Fokusering: koaksial fin- og grovinnstilling i ett grep.
Preparatsikring: innebygget sikring mot utilsiktet ødeleggelse av mikropreparater ved fokusering.
• Kryssbord: integrert kryssbord med lavthengende, koaksial betjening.
Leveres med støvhette og immersjonsolje
• Størrelse: 34 cm x 17 cm x 34 cm.





Mikroskop BioBlue binokulært, semiplan


Mikroskop Bioblue monokulært digital 5 MP

Påkostet og eksklusivt mikroskop fra nederlandske Euromex. Egner seg ypperlig som demonstrasjonsmikroskop i ungdomsskolen og som elevmikroskop i biologikursene i videregående skole og høgskole.
I BioBlue får man et mikroskop som både mekanisk og optisk utmerker seg og semiplan objektiver sikrer skarpt bilde helt fra sentrum til randsonen uansett forstørrelse. Regulerbar NeoLED belysning med ekstra stort lysutbytte er standard på de binokulære og trinokulære mikroskoper.
BioBlue finnes i ulike kombinasjoner slik at du kan finne modellen som passer akkurat til ditt behov. Dette er den klassiske modellen for videregående skole, med objektiver 4, 10, 40 og 60x og 10x WF okular. Mikroskopet kan også skaffes med andre spesifikasjoner.
Mikroskop Fokus Serie
Påkostet og eksklusivt mikroskop fra nederlandske Euromex. Egner seg ypperlig som demonstrasjonsmikroskop i ungdomsskolen og som elevmikroskop i biologikursene i videregående skole og høgskole. I BioBlue får man et mikroskop som både mekanisk og optisk utmerker seg og semiplan objektiver sikrer skarpt bilde helt fra sentrum til rand sonen uansett forstørrelse. Regulerbar NeoLED belysning med ekstra stort lys utbytte er standard på de binokulære og trinokulære mikroskoper.
BioBlue finnes i ulike kombinasjoner slik at du kan finne modellen som passer akkurat til ditt behov. Dette er den klassiske modellen for videregående skole, med objektiver 4, 10, 40 og 60x og 10x WF okular. Mikroskopet kan også skaffes med andre spesifikasjoner.
Flott, brukervennlig elevmikroskop som dekker de fleste behov til og med biologi-kursene i videregående skole. Monokulært hode med trinnløs justerbar LED-lyskilde. Skarptegnende objektiver gir sammen med okular 10x forstørrelsene 40, 100, 400 og 600x. Høy mekanisk kvalitet på så vel heisverk som kryssbord. Mikroskopet kan også leveres med binokulært eller trinokulært hode og med 40, 100, 400 og 1000x forstørrelse
Spesifikasjoner:
• Okulartubus: monokulært/ Binokulært/ Trinokulært (45° vinklet).
Hodet er 360° roterbart.
• Okular: 10x ekstra vidvinkel (WF10x/18mm).
Objektivrevolver: bakovervendt med plass til fire objektiver.
Objektiver: akromatiske (4x/N.A. 0.10, 10x/N.A. 0.25, 40x/N.A. 0.65/S, 60x/N.A. 0.85/S).
Forstørrelser: 40x, 100x, 400x og 600x Kondensor: Abbé-kondensor (N.A. 1.25) med filterholder. Justérbar i høyden.
Blender: irisblender for trinnløs regulering av lysstyrke, kontrast og dybdeskarphet.
Belysning: LED (3 W) med trinnløs regulering.
Fokusering: koaksial fin- og grovinnstilling i ett grep.
• Preparatsikring: innebygget sikring mot utilsiktet ødeleggelse av mikropreparater ved fokuserin.

Kryssbord: integrert kryssbord med lavthengende, koaksial betjening.
• Leveres med støvhette.
Størrelse: 25cm x 21,5cm x 37cm.



Stereolupe Edublue Digital
En flott og påkostet modell fra nederlandske Euromex. Stereolupen kjennetegnes av skarptegnende optikk, solid mekanikk og kraftig LEDlys. Den har innebygget kamera som gjør at du kan tilkoble storskjerm slik at hele klassen kan se samtidig. Ta bilder og video og bruk det i digitale rapporter og presentasjoner. Drives av oppladbare batterier (inkludert)
Spesifikasjoner:
• Programvare: Inkludert ImageFocus Plus
Forstørrelser: 10x, 20x og 40x.
Objektiver: 1x, 2x og 4x, montert i standard revolverfatning.
• Okularpar: 10 x WF
Belysning : LED over og under, trinnløs regulerbar
• Leveres med standard strømkabel som kobles til strømnettet (100-240 V)
• Inkludert er øyemuslinger, mattglasskive (gjennomlysbar) og kontrastskive (sort/hvit)


Varenr.: Pris
307090 7895,-
Stereolupe Fokus, 10x,20x og 30x
Stereolupe Fokus, 10x,20x og 40x
Vår Fokusserie vokser og vi kan nå oppfylle mange læreres drøm med stereoluper med tre faste forstørrelser. Stereolupen har trinnløst regulerbart LED-lys og innebygde batterier. Det gjør at man enten kan bruke lupen koblet til strømnettet eller utnytte muligheten til å slippe kabler og skjøteledninger i klasserommet. Man kan velge mellom overlys eller underlys som justeres trinnløst. Objektivene er montert i dreibar revolverfatning og gjør det enkelt å veksle mellom ulike forstørrelser.
Spesifikasjoner:
Forstørrelser: 10x, 20x og 30x/ 40x.
• Objektiver: 1x, 2x og 4x, 1x, 2x og 3x montert i standard revolverfatning.
Okularpar: 10 x WF
Belysning : LED over og under, trinnløs regulerbar
• Leveres med standard strømkabel som kobles til strømnettet (100-240 V) Inkludert er øyemuslinger, mattglasskive (gjennomlysbar) og kontrastskive (sort/hvit)

307044 10x,20x,30x 2290,307045 10x,20x,40x 2290,-
Stereolupe 40B, 10x/30x
Stereolupe 40C, 20x/40x
Flott stereolupe i god kvalitet - spesielt velegnet for yngre elever. Denne stereolupen har halogenlys over- og underlys (12V/10W) og objektiver som gir 10x og 30x /20x og 40x forstørrelse. Forstørrelsen endres ved å vri på objektivtubus.Hodet er dreibart og dermed kan to elever lett dele en lupe. Forstørrelsen gir et stort bildeutsnitt slik at yngre elever lettere gjenkjenner detaljer i det fysiske objektet de ser på. Stereolupen leveres med okularkapper, støvhette og svart/hvit plate.

Varenr.: Størrelse Pris
307024 40B, 10x/30x 1890,307025 40C, 20x/40x 1890,-


Mikropreparatsett, Plantecellen, 10 preparater
Celler med krystallform fra kaktus, tverrsnitt
Hyllebær (Sambucus), stengel, tverrsnitt
• Filtkongslys (Verbascum), bladhår som beskytter mot sollys
Rosmarin, kjertelceller i blad, tverrsnitt
• Solsikke (Helianthus), blad med hår, tverrsnitt
Vannlilje (Nymphaea), stengel med hår i aerenkyma (luftfylt vev), tverrsnitt
• Døvnesle (Lamium), stengel med kollenkymceller (strukturelle støtteceller), tverrsnitt
• Potet (Solanum), knoller med stivelsekorn, tverrsnitt
Pollenkorn fra ulike arter
Ledningsvev fra plantestengler, ringformet, spiralformet m.fl.
Varenr.: Pris
307159 790,-

Biologi, grunnsett for skolen, 10 mikropreparater
Grønnalge fra ferskvann som viser kloroplaster
Muggsopp fra brød med mycel og sporer
Solsikke rot, tverrsnitt
Liguster, blad som viser palisade- og parenkymvev, tverrsnitt
• Tulipan, fruktknute, tverrsnitt t.s.
Tøffeldyr (Paramecium), flimmerdyr
• Meitemark, tverrsnitt av midten
Vanlig flue, hel vinge
• Frosk, blodutstryk som viser blodceller med kjerne
Kylling, hud med fjær, lengdesnitt
Mikropreparatsett, Dyrecellen, 10 preparater
Enkle dyreceller fra salamander lever (t.s.)
• Epitelceller fra innside av munnen hos menneske
Epitelceller fra tarmvegg
• Pigmentceller fra hud Fettvevceller
Bindevevceller (i ledd)
Muskelceller
Nerveceller
• Blodceller
Celledeling, mitose
Varenr.: Pris
307156 790,-

Mikropreparatsett, Bakterier, 10 preparater
• Stavbakterier (Bacillus subtilis)
Melkesyrebakterier (Streptococcus lactis)
Stavbakterier fra tarm (Proteus vulgaris)
• Tarmbakterier (Escherichia coli)
Paratyfusbakterier (Salmonella paratyphi)
• Dysenteribakterier (Shigella dysenteriae)
Skarlagensfeberbakterier (Staphylococcus pyogenes)
• Bakterier fra munnen hos menneske
Bakterier fra ost Bakterier fra surdeig Varenr.:

Tøffeldyr (Paramecium), makro- og mikrokjerner

307165 175,-

Meiose, tverrsnitt, lilje (Lilium)

307164 185,-


Mitose, lengdesnitt, rotspiss av løk (Allium)

307163 165,-

Blodutstryk, menneske, røde/hvite blodlegemer

307162 125,-


Oksygenmeter med probe
Brukervennlig, kompakt og prisgunstig instrument for å måle oppløst oksygen i vann.
Spesifikasjoner:
Måleområde: 0-19,9 mg/lO2. Viser 0,1 mg/lO2
Nøyaktighet: 1,5%.
• Enkel kalibrering.
Automatisk temperaturkompensasjon.
Enkelt å bytte membran.
• Batterier: 1 stk. 9V.Følger med.
Mål: Instrument: 150 x 80 x 40 mm. Probe: diam. = 33 mm, lengde = 163 mm. Probeledning: 3 m.
Vekt: Instrument: 215 g. Probe: 380 g.
Utstyr som er inkludert: Elektrodebeskyttelse, reservemembraner, O-ringer, elektrolytt og kalibreringsløsning følger med


pH-meter/ORP/temperatur,vanntett
Et utmerket pH-meter for skoler, høgskoler og profesjonelle brukere. Vanntett (IP67), bærbar 3-i-1 ph/ORP/temperatur til bruk i mange sammenhenger. Opp til 3-punktskalibrering og med 7 standardbuffervalg kan instrumentet raskere og enklere kalibreres til en høyere nøyaktighet sammenliknet med et- eller topunktskalibrering. Resultatet avleses i det store todelte LCD-displayet. Leveres i praktisk oppbevarings- og transportkoffert. Instrumentet er batteridrevet og batterier er inkludert.
Spesifikasjoner:
• pH-elektrode: Inkludert: pH-elektrode med beholder for trygg lagring
Temperatursensor i pH-elektroden
• Nøyaktighet: ± 0.02 pH | +/-0.5°C
Måleområde utvidet: -2.00 pH to 20.00 Ph
Måleområde elektrode: pH 0-12
• Strøm: Batterier 3 x AA inkludert (Ca. 200 timers bruk)
Manual: Inkludert (engelsk)
Ekstra kabel. 3 m. forlengerkabel for ekstra fleksibilitet.
• Innebygget klokke/dato for registrering av for eksempel kalibrering.
Vekt: 260 g. inkludert batteri

pH-strips Macherey Nagel
pk a 100 strips
Boks med 100 strips som måler pH mellom 0 og 14. Fargeresultatet på stripsen sammenlignes med ”fargeskala-fasit” på boksen for å bestemme riktig verdi.

pH-papir 0-14, strips økonomi
pk a 100
Boks med 100 strips som måler pH mellom 0 og 14. Fargeresultatet på stripsen sammenlignes med ”fargeskala-fasit” på boksen for å bestemme riktig verdi.

pH-papir 0-14, rull økonomi
pk a 100
Boks med 5 meter pH-papir på rull som måler pH mellom 0 og 14. Fargeresultatet på stripsen sammenlignes med ”fargeskala-fasit” på boksen for å bestemme riktig verdi.



Vekt, 1000 g/0,1 g økonomi
Dette er en meget god digitalvekt som leveres ferdig kalibrert fra fabrikk. Vekta kan enkelt nullstilles og den innehar også tellefunksjon.
Spesifikasjoner:
• Veieområde: 0-1000g
Nøyaktighet 0,1g
Batterier er inkludert.

Brukervennlig, prisgunstig vekt fra tyske Kern som opereres med kun to knapper. Veieområde 2200 g, nøyaktighet 1 g Ideell for skolebruk. Batteridrievet (batterier inkludert).
Spesifikasjoner:
• Veieområde 2200 g, nøyaktighet 1 g
Enkel og behagelig betjening med bare to knapper.
Slank og smal og tar opp lite plass.
• Slår seg automatisk av når den ikke brukes.
Med gummiføtter
Størrelse : Veiepanne Ø Høyde 35 mm
• Garantie 3 år


Brukervennlig, prisgunstig vekt fra tyske Kern som opereres med kun to knapper. En glimrende vekt for de som ønsker en vekt med begrenset veieområde og stor nøyaktighet. Veieområde 100 g, nøyaktighet 0,001 g Ideell for skolebruk. Batteridrievet (batterier inkludert).
Spesifikasjoner:
Veieområde 100g, nøyaktighet 0,001 g
• Enkel og behagelig betjening med bare to knapper.
Slank og smal og tar opp lite plass.
Slår seg automatisk av når den ikke brukes.
• Med gummiføtter
Størrelse : Veiepanne Ø Høyde 35 mm
Garanti 3 år

Vekt, 300 g/0,01 g med hus, økonomi
Prisgunstig vekt for kjemikurset eller hvor høy nøyaktig er påkrevet. Vekta har baklyst display og store lettleste tall. Leveres inkludert veiehus (hull i lokket) for å unngå at luftens bevegelseer påvirker målingen.
Spesifikasjoner:
Veieområde: 0-300g
Nøyaktighet: 0,01g
• Batterier er inkludert.

500 g/ 0,01 g, Kern EHA 500-2
Utmerket, nyutviklet skolevekt for kjemiundervisning og naturfag generelt. Vekta har stor nøyaktighet (0,01 g), er responsrask og gir repeterbare resultatet. Du kan veksle mellom ulike enheter og vekta kan også brukes som en tellevekt. Vekta har justererbare gummiføtter, veiepanne av stål og en kompakt og moderne utforming. Oversiktelige knapper gjør det enkelt både å kalibrere og tarere.
Spesifikasjoner:
Måleområde: 0 - 500 g
• Oppløsning: 0,01 g
Veieplate: 105 mm i rustfritt stål
Strømkilde: strømkabel (inkludert) eller batteri (9V batteri, ikke inkludert)


620 g / 0,001 g, Kern PNJ 600-3M
Presis og brukervennlig presisjonsvekt fra tyske Kern som leveres inkludert ekstra stort veiehus. Veiehuset har 3 skyvedører gir enkel tilgang til veiepanna og det som innveies.Innebygget kalibreringslodd gir maksimal enkel kalibrering, økt presisjon og gjør vekta godt egnet til mobil bruk. Vekta har stort og lettlest LCD-display med indikator som viser gjenværende veiekapasitet. Den benytter et ekstra følsomt «tuning fork» system noe som gir økt nøyaktighet og rask innveiing. Kan brukes som tellevekt (totalantall) og har prosentvisning.
Spesifikasjoner:

Veieområde 620 g, nøyaktighet 0,001 g (1 mg).
Inkludert veiehus med 3 skyvedører.
• Enkel kalibrering med innebygget kalibreringsvekt.
Veiepanne Ø 140 mm.
• Størrelse 172 x 171 x 160 mm (b x l x h).
Batteridrift med nettadapter inkludert.
• Garanti 3 år.


Elektroforeseapparat, phorEasy med visualiseringsystem
Et komplett, kompakt og genialt system som vil forenkle gelelektroforese, fremkalling og analyse i ethvert klasserom. Apparatet kommer komplett med spenningskilde, elektroforeskar og blue LED visualiseringssystem (transilluminator). Her er fordelene mange i forhold til tradisjonelt utstyr og gjennomføring. Følg separasjonen undervis
360° Innsyn
Elektroforesen er ferdig på kun 5-15 minutter
Ingen løse kabler og koblinger
Redusert forbruk av gel og buffer
Nettadapter og lav spenning reduserer risiko
Visuell analyse eller med gratis programvare
Spesifikasjoner:
Base med integrert spenningskilde, transilluminator og filterlokk
Grafitt elektroder
Form til gelstøp, 1 kam; 6 eller 9 brønner
Spenning: 48 V
Inkludert oppbevaringskoffert



Spenningskilde til elektroforese



Elektroforese, sett med spenningskilde og elektroforesekar
Kompakt og brukervennlig spenningskilde som kan brukes med en eller to elektroforesekar. 70 V eller 140 V. Dobbel utgang med sikkerhetsbøssinger (to elektroforesekar samtidig)

308058 2629,-
Elektroforesekar
Solid elektroforesekar med sikret lokk spesielt utviklet for undervisningsbruk. Inkludert er sikkerhetskabler for tilkobling til spenningskilde.Leveres komplett med gelkar og kam (inntil 10 prøver samtidig). Inkludert kar med vegger for støping.
• Størrelse (l x b x h) : 22,5 x 9,7 x 8,5 cm

Varenr.: Pris
308062 2035,-
Komplett sett til elektroforese inneholdende sett med spenningskilde og elektroforesekar. Egner seg godt til DNA elektroforese med agarose gel og protein elektroforese . Utstyret er enkelt i bruk og godt sikret. Kan brukes med de fleste undervisningssett sett som tilbys til skolemarkedet.
Spesifikasjoner:
• Spenningskilde: 70 V eller 140 VDobbel utgang med sikkerhetsbøssinger (to elektroforesekar samtidig)
Elektroforesekar: Solid elektroforesekar med sikret lokk spesielt utviklet for undervisningsbruk.Inkludert er sikkerhetskabler for tilkobling til spenningskilde. Leveres komplett med gelkar og kam (inntil 10 prøver samtidig). Inkludert kar med vegger for støping.
• Størrelse (L x l x h) : 22,5 x 9,7 x 8,5 cm

308057 3950,-

PCR maskin for undervisning

Nyutviklet PCR-maskin utviklet for undervisningsformål. En PCR-maskin åpner mange nye muligheter innenfor bioteknologi, men har tradisjonelt vært for dyre for vanlige skolebudsjetter. Dette er en PCR-maskin som ikke er forbeholdt forskere og universiteter og vil gi muligheter til mange spennende forsøk innenfor genteknologi og PCR også i videregående skole.
Spesifikasjoner:
• Display og ratt for innstilling og overvåking av termosykler.
6 PCR-rør a 0,2 ml
• Størrelse 225 x 140 x 100 mm
Antall forhåndslagrede programmer: 3
Antall mulige temperatursykler: 1-99
• Temperaturområde: 6 °C - 99 °C
Nøyaktighet display 0,1°C
• Reguleringsnøyaktighet +/- 0,2 °C
16490,-

Brukervennlig mikropipette i høy kvalitet. Ved hjelp av hjulet i enden av pipetten stiller man enkelt inn riktig sugevolum som leses av på displayet. Ergonomisk grep og mekanisme som løser ut pipettespissen. Hver pipette har et serienummer og er testet i henhold til ISO8655. Kalibreringssertifikat medfølger. Pipettespisser bestilles separat.
Mikropipette, justerbar, 2-20 µl
Volum: 2-20 ul
• Trinn: 0,5 ul
Lengde: 24 cm
Mikropipette, justerbar, 20-200 µl
• Volum: 20 – 200 ul
• Trinn: 1 ul
Lengde: 24 cm
675,-
10%

Mikropipette, justerbar, 100-1000 µl
• Volum: 100 – 1000 ul
• Trinn: 5 ul
Lengde: 24 cm
Mikropipette, justerbar, 1000-5000 µl
• Volum: 1000 – 5000 ul Trinn: 50 ul
• Lengde: 24 cm

Pasco har startet å utvikle en serie produkter som kombinerer tradisjonell naturfag med sensorer og teknologi for koding og styring. Dette passer godt for norsk læreplan og kodingen nettopp skal styrke naturfagene.

Pakken inkluderer:
• 1x Økokammer (ME-6667)
• 1x //control.Node (PS-3232)
1x Drivhussensor (PS-3322)
• 1x USB Vifte(PS-6206)
1x USB Vannpumpe(SE-6208)
1x PASCO Vekstlys (PS-3347)
• 1x Strømutgangenhet (PS-3324)
1x Drivhus tilleggsutstyr (PS-3348)
Antakelig den mest avanserte og imponerende modellen av et drivhus som er laget for skolebruk. Spekket med teknologi for å måle temperatur, lys, relativ luftfuktighet og jordfuktighet. Målingene kan deretter brukes i kode til å tilføre frisk luft, vann og lys for å til enhver tid ha optimale forhold i drivhuset. Perfekt som et større prosjektarbeid hvor man vil studere biologiske og økologiske prosesser. Produktet gir mange muligheter og til tross for kompleksiteten er det overraskende enkelt å bruke. Norsk veiledning og eksempelkode er inkludert.
• Vi tilbyr gratis webinar eller workshop som får deg raskt i gang!
• Inkludert er også en norsk manual hvor hver enhet behandles individuelt før man setter alt sammen og tar i bruk alle muligheter.



EcoZone økosystem

Et lukket akvatisk/terrestrisk økosystem. Gjør målinger over tid med datalogger og mange forskjellige sensorer uten å forstyrre systemet. Mål for eksempel oksygen, karbondioksid, temperatur, luftfuktighet og lys i terrariet. Mål oksygen, pH, temperatur, ledningsevne m.m. i akvariet. Vi anbefaler EcoZone i prosjekter generelt og gjerne også ToF. Vi minner om at de nye trådløse sensorer har innebygget minne og egner seg godt til langtidsmåler med systemet.

Hold systemet lukket ved prøvetaking som gjøres med den inkluderte sprøyten. Eller foreta injeksjoner og undersøk hvordan økosystemet responderer.

Observer syklusen av fotosyntese og respirasjoni det simulerte mikroklimaet EcoZone lager og observer effekten på karbondioksid-konsentrasjonen.

Åpninger med gummimansjetter muliggjør interaksjon mellom levende og ikke levende komponenter og den inkluderte bomullstråden transporterer vann mellom de ulike kamre.

NÅ 2985,-
Spar 20%

ME-6668 EcoZone System inkluderer
3 x individuelle økokammer med lokk
Fot for å samle de tre kamre i et system
• Propper og koblinger
Tykk bomullstråd
• Plastsprøyte og slange
Temperatursensor med display, trådløs
PASCOs nye temperatursensor med display kombinerer alle de sterke egenskapene til en trådløs sensor med et klart og lettlest display. Som før kan du logge data og se dem i sanntid på din dataskjerm eller mobile enhet (nettbrett eller smarttelefon). Du kan også logge data til det integrerte minnet uten å være tilkoblet noen enhet for senere å laste over og analysere data. Batteriet vil holde til mange måneders datainnsamling hvis målefrekvens ikke settes for høyt.

pH-sensor med display, trådløs
Den trådløse pH-sensoren med display egner seg godt for alle kurs i kjemi, biologi eller naturfag. Sensoren kan brukes både i laboratoriet og ute i felten, og du slipper å bruke kabler, noe som gjør bruken og eksperimentoppstillinger enklere og sikrere. Med et oppladbart litiumionbatteri kan enheten brukes i årevis med normal klassebruk. Den lett lesbare OLED-skjermen (organisk lysdiode) gjør det mulig for elevene å undersøke løsningens egenskaper umiddelbart, med eller uten datagrensesnitt. Den trådløse pH-sensoren kan brukes til utallige aktiviteter, eksempelvis syre-base-titreringer, undersøkelser av husholdningskjemikalier, analyser av kjemiske reaksjoner, studier av vannkvalitet og mye mer.

Fotosyntesekammer
Et komplett fotosyntesekammer med styring av lys og temperatur. Med dette kammeret kan kan elevene gjøre tradisjonelle fotosyntese eksperimenter i et kontrollert akvatisk miljø. Lokket i kammeret har hull for sensorer og inkludert er propper for å «lukke» systemet når sensorene ikke er i bruk. Et klart indre kammer tillater full eksponering for sollys mens et ugjennomsiktig (opakt) ytre dekselkammer blokkerer lys. Ni separate LEDlys (hvitt, rødt, grønt eller blått) lar elevene teste variabler som lystype og plantenæringsopptak og eliminering.


Ledningeevnesensor med display, trådløs Den trådløse ledningsevnesensoren er et funn for deg som både vil ha sensorens sterke egenskaper sammen med et selvstendig instrument! Dette gir deg muligheten til å ta raske enkeltmålinger hvor du leser av resultatet i displayet eller «streame» data i sanntid til en dataskjerm eller en mobil enhet (smarttelefon eller nettbrett). Som for alle PASCOs trådløse sensorer har den innebygget minne som gjøre at du kan logge i timer, dager eller uker.


Oppløst oksygengass sensor, trådløs
Rask, nøyaktig sensor for måling av oppløst oksygen på lab eller i felt. 3 m. lang kabel med vanntett sonde gjør at den også kan senkes ned i vann. Krever ingen elektrolytt og avansert kalibrering. Sensoren har innebygget minne for langtidsmåling og er som alle PASCOs sensorer kompatibel med Capstone og SPARKvue.



GM sensor, trådløs
PASCOs trådløse GM sensor detekterer alfa, beta og gamma stråling. Den er solid laget med et metallnett som beskytter vinduet foran GM-røret. Lydsignal kan skrus av og på. Høyspenningen til GM-røret inne i telleren kan kontrolleres trådløst. Med denne sensoren blir det enda enklere å sette opp forsøk med halveringstid, omvendt kvadratisk lov, materialers evne til å bremse forskjellige typer av ionisert stråling, m.m. Sensoren har oppladbart batteri og minne.

Jordfuktighet sensor, trådløs
Den trådløse jordfuktighetsensoren måler volumetrisk vanninnhold (%VVI) i jord, og kan vise data i sanntid eller programmeres til å lagre langtidsmålinger i sensorens innebygde minne. Den er solid og enkel å bruke, og passer like godt til kontrollerte forsøk på laboratoriet (f.eks i et ME-6668 EcoZone system), som langtidsmålinger på feltarbeid. La elevene utforske fordampning i forskjellige jordprøver, forskjellige planters vannforbruk i løpet av døgnet osv.
4745,Spar 10% NÅ 2646,Spar 10%

Prøveholder for GM-sensor
Denne holderen sørger for et enkelt oppsett og posisjonskontroll for PS-3238 Trådløs GMsensor. Røret i fronten av sensoren passer perfekt inn i prøveholderen, og gjør at røret står nøyaktig 1 cm over det øverste av 8 spor for absorbsjonsplater, alle med 1 cm mellomrom. Det følger med fem 7 x 7 cm aluminiumplater, samt en skuff for radioaktive prøver.



Smart Gate Dynamics System, trådløs
Med PASCOs nye Wireless Smart Gate dynamic system kan du gjøre de samme målingene som den klassiske telleren, enklere mer presist og med flere muligheter. Et godt eksempel er det klassiske fysikkforsøket hvor vi ønsker å måle to hastigheter og tiden mellom målingene for en vogn som beveger seg på en dynamikkbane. Sett opp utstyret som vist på bildet og koble sammen.
• Bane og vogner er ikke inkludert
Som for alt annet av PASCO sensorer er oppsettet enkelt og intuitivt både i SPARKvue og Capstone


904,Spar 10%
Ladningssensor, trådløs
Sensoren er utviklet for å måle elektrostatisk ladning på et objekt og egner seg godt for fysikkursene i videregående skole eller i høyere utdanning. Mål ladning eller spenning og vis dataene grafisk, digitalt, i tabell eller med viserinstrument. Koble enkelt til for eksempel et Faraday bur ved hjelp av den inkluderte BCN-krokodilleklips kabelen. Inkludert også en E-felt sensor for relative målinger





Smart Gate dobbel lysport, trådløs
Dette er den mest avanserte lysporten på markedet og muliggjør mange flere og mer nøyaktige målinger enn de tradisjonelle modellene. Bruk fotocellen med enten SPARKvue eller Capstone, sett den opp selv eller bruk de smarte snarveiene for typiske forsøk. Du kan koble til flere lysporter, Supertrinse eller flygetidsplate. Slipp en Picket Fence gjennom og få lynraskt falltid med ulike «mellomtider». For store objekter kan du også kombinere med en laserpeker og måle utgangshastigheten til for eksempel en rakett!
Typiske anvendelser:
Utgangsfart ved skrått kast
• Tidsmålinger med dynamikkvogner
Rotasjonsmålinger (sammen med en Supertrinse)
Tidsmålinger med pendel
• Tyngdens akselerasjon med stakittlinjal
Varenr.: Pris
NÅ 2033,Spar 10%

Kraftplatform
En solid kraftplatform med 4 kraftsensorer innebygget. Måleområde -1100
N til + 4400 N. Oppløsning 0,1 N. Plattform størrelse 35 x 35 cm, vekt 4 kg.
Mål impulsstøt fra personer og store baller, mål kraft på en person i heisen m.m.
NÅ 9468,-
Spar 20%


PS-2141 11835,-
Standard Smart Cart/Metal Track 1,2m System
Kastekanon, liten
PASCOs kastekanoner kjennetegnes ved at de er enkle å stille opp,er åpne og enkle å forstå og gir repeterbare kast. Denne modellen er lærernes favoritt og kan stilles inn i tre ulike kastelengder (0,5m - 1m - 2m) og justeres fra horisontalt kast til vertikalt, 0 - +90 grader og også negativ vinkel 0 - -45 grader. Kanonen har vinkelavleser. Kanonen kan påkobles fotocelle (ekstrautstyr) for måling av utgangsfart og man kan også tilkoble flygetidsplate (ekstrautstyr) for å måle tiden fra utskyting til nedslag.

NÅ 2759,-
ME-6825B 3066,-
Flygetidsplate
I forsøk med fritt fall og kast (skrått og horisontalt) ønsker man ofte å måle flygetiden, det vil si tiden fra objektet forlater kastekanonen eller fritt fall apparatet og til det treffer underlaget.Flygetidplaten kan brukes med alle PASCOs kastekanoner og fritt fall-apparater og kobles med kabel sammen med fotocellen for måling av flygetiden.

NÅ 1517,Spar 10%
ME-6810A 1685,-
Et komplett dynamikksystem som inkluderer bane 1,2 m. i metall, to Smart Carts og standard tilbehør. Du kan med dette settet gjøre alle de klassiske øvelser i mekanikken som for eksempel Newtons tre lover og støtforsøk elastisk og uelastisk, oscillerende bevegelse, forsøk med friksjon, klassiske snordrag øvelser med mer.
Pakken inkluderer:
• 1x Smart Cart (Red) (ME-1240)
• 1x Smart Cart (Blue) (ME-1241)
1x Cart Mass (Set of 2) (ME-6757A)
• 1x Metal Track 1.2 m (ME-9493)
1x Dynamics Track End Stop (2 pack) (ME-8971)
1x Adjustable Feet (2) (ME-9872
• 1x Dynamics Track Spring Set (ME-8999)
1x Super Pulley with Clamp (ME-9448B)
1x Angle Indicator (ME-9495A)
• 1x Friction Block (ME-9807)
1x Track Rod Clamp (ME-9836)
NÅ 11645,-

Spar 15%
Varenr.: Pris
ME-5718 13700,-

Temperatursensor, trådløs
Mål temperatur på en helt ny måte! Med en trådløs sensor får du målingene direkte inn på din smarttelefon, nettbrett eller PC/Mac mens du måler. Vis målingene grafisk, i tabell eller i et digitalt format. Programvaren SPARKvue er på norsk og gratis for mobile enheter. Måleområde -45-145 grader C.
Eksempler på forsøk som er ligger ferdig på www.labdidakt.no
• Eksoterme og endoterme reaksjoner
Is – vann – damp
Avkjøling
• Fordampning av alkoholer
Hvordan fungerer en solfanger


pH-sensor, trådløs
Det eneste du trenger for å måle pH med et nettbrett, smarttelefon eller datamaskin er denne sensoren og programmet SparkVue eller Capstone! Sensoren kan settes opp for frittstående logging, og den tåler til og med en tur under vann (IP 67 standard)!
Oksygen gass sensor, trådløs
Sensoren måler konsentrasjonen av O2-gass, samt luftfuktighet og lufttemperatur. Den passer til forsøk med fotosyntese, respirasjon og andre miljøundersøkelser. Sensoren har eget minne og kan settes opp til datalogging på lab og i felt i timer og dager. Måleområde 0-100% oksygen gass konsentrasjon ±1% .
Utbyttbart batteri gir opp til et års brukstid. Sensoren kan også benytte andre gel-elektroder med kabel og BNC-kobling.
• Måleområde: 0-12 pH +/- 0,1
Batteri: CR2032 (kan byttes)
Ekstern logging: Ja







• pH probe: Gel Ag-AgCl kombinasjonselektrode m/BNC
PS-3204 2438,-

4583,-






Varenr.: Pris
PS-3201 1560,-



Alle PASCOs trådløse sensorer har innebygget minne for langtidsmåling. NÅ 1326,-
CO2 sensor, trådløs
Mål konsentrasjon av CO2 gass i lukkede systemer eller åpne miljøer. Undersøk fotosyntese, respirasjon og karbonsyklus. Data kan logges over lang tid direkte til sensorens minne. Oppladbart batteri. 250 ml prøveflaske og USB-ladekabel inkludert. Ingen krevende kalibrering er nødvendig. Måleområde: 0 -100000 ppm.

PS-3217 5092,Varenr.: Pris
PS-3208 5379,-
CO2-konsentrasjon og temperaturøkning. Økokammer
I dette oppsettet inngår to temperatursensorer, en CO2-sensor og Eco Zone system (ME-6668). I løpet av få minutter kan du vise hvordan økt CO2-konsentrasjon i det ene kammeret fører til raskere temperaturøkning.
Du behøver:
1 x PS-3208 Trådløs CO2-sensor
• 2 x PS-3201 Trådløs Temperatursensor.
2 x ME-6667 Økokammer
I tillegg behøver du samarin og en lampe som avgir varme.
Lukket kammer hvor sensorer kan tilkobles for kvantitative studier av for eksempel gjæring eller fotosyntese. Scan
ME-6667 1111,-



Spektrometer (Bluetooth 4/USB)
Med PASCOs spektrometer kan man gjøre forsøk med intensitet, absorbans, transmittans og fluorescens (to eksitasjonsbølgelengder: 405 og 500 nm). Spektrometeret kan kobles til PC, Mac, iPad og Android nettbrett (Android fra v1.1) med enten USB kabel eller blåtann. Båndbredde 380-950 nm, 2-3 nm FWHM. Leveres med programvare og 10 stk kuvetter.


Spektralrørholder
Holder for spektralrør ca. 26 cm. Fjærbelastet oppe og nede for enkelt innsetting av rørene. Malt med matt maling bak rørene for å unngå uheldig refleksjon. En dør med spalte må lukkes for at spenningen skal kobles til så apparetet er svært trygt å bruke. Apparatet er CE/CSA og CUS godkjent.






Fiberoptisk kabel
Den fiberoptiske kabelen er utviklet for bruk sammen med PASCOs spektrometer PS-2600A. Kabelen kobles til kyvetteholderen og den andre enden peker mot lyskilden. Du kan da se emmisjonsspekteret fra blant annet spektralrør, lamper og lasere. I programmet Spectrometry (gratis) ligger det kjente emmisjonsspektre man kan sammenlikne med og identifisere lyskilden!

I vårt Infosenter finner du et kortfattet dokument på norsk om bruk av spektrometeret sammen med gratis programvaren « Spectrometry».



PASCO Smart Cart, et komplett læremiddel for dynamikken!
Den er bygget over samme lest som tidligere dynamikkvogner fra PASCO, den går på de samme banene og de nesten friksjonsfrie hjulene er av beste kvalitet. Den har sensorer for å måle posisjon, fart, akselasjon og kraft. Sensorene kan brukes samtidig og målefrekvensen styres individuelt for optimale resultater. Bruk Smart Cart med Capstone eller SPARKvue.
• Innebygget +/-100 N kraftsensor
3-akset akselerometer
• Bevegelsessensor (måler posisjon og fart, med eller uten bane)
Bluetooth tilkobling (ingen datalogger nødvendig)
Oppladbart batteri
• Magnetisk støtdemper for kraftsensoren
3-posisjons utskyter Plass til vekter/lodd
• Borrelåser
Kraftsensor krok og gummipute
• Løs USB-kabel for å lade batteriet

Trådløs Smart vifte for Smart Cart eller andre PASCO-vogner er nok en spennende innovasjon fra PASCO. Viften kan trådløst kontrolleres fra PASCOs programvarer (Capstone og SPARKvue) og gir mange nye muligheter brukt sammen med alle PASCOs dynamikkvogner.

Ballistisk utskyter til dynamikkvogn, ny

Smart Cart vektordisplay
Smart Cart vektordisplay festes med en fingerskrue og kobles til Smart Carten. Det synliggjør kraft, akselerasjon eller hastighet til din Smart Cart. Velg i SPARKvue eller Capstone om det er kraft, akselerasjon eller hastighet som skal vises og juster eventuelt skalaen slik at det passer til ditt forsøk. Rød eller grønn pil og antall piler angir retning og mål på verdien som vises.

Smart Cart Motor
Den ballistiske utskyter fra 1994 har kommet i en ny utgave for Smart Cart. Settes vogna i bevegelse skytes kula ut vertikalt og denne vil ha samme hastighet som vogna, uavhengig av gravitasjonen. Dette er et viktig prinsipp! Kula vil følge en parabel og lande i vogna og slett ikke bli «frakjørt» slik man intuitivt kan forvente. Den nye ballistiske utskyteren har et kontrollpanel i programvaren tilsvarende den nye smartviften.


Ny motor som koples på Smart Cart og styres fra Capstone eller SPARKvue. Gir muligheter for mange fine forsøk i mekanikk og egner seg godt for oppgaver med koding. Med denne motoren kan du kontrollere Smart Carten til å ha konstant hastighet eller akselerere. Egner seg godt for øvelser med friksjon.


Rubens flammerør
En virkelig spektakulær og flott demonstrasjon av stående bølger! Produktet består av et 100 cm langt metallrør med 29 hull på toppen. I enden av røret er det montert en høyttaler hvor man kan tilkoble en funksjonsgenerator, som justert vil gi deg en stående bølge. Derfra kan du bestemme bølgelengde og lydhastighet. Man kan også tilkjøpe 107107 Musikkadapter for Rubens tube og la musikken fra for eksempel en


Lydssensor, trådløs
Den trådløse lydssensoren er to sensorer kombinert i en, og du definerer enkelt hva du vil fokusere på i ditt forsøk, lydbølger/frekvens eller lydnivået (intensitet). Sensorer registrerer endringer i lufttrykket og visualiserer på den måten lydbølger og lydnivået måles presist i en vektet skala både for dBA og dBC. Bruk gjerne sensoren med oscilloskop og FFT-funksjon i Capstone og SPARKvue.

Stemmegafler på resonansskasse
To stemmegafler montert på hver sin resonanskasse. Hør hvordan lyden forsterkes av kassen og lag spennende lydbilder når begge gaflene settes i svingning!
Spesifikasjoner:
Inkludert to resonanskasser, to stemmegafler (440 Hz), en løper for frekvensendring og en gummiklubbe.
• Materiale: Resonanskasse av tre, stemmegafler av stål. Mål: Resonanskasse: 17 x 9x 5 cm. Stemmegafler: 16 cm lange.

Trådløs forsterker for Rubens
Lascells trådløse Rubens-rørforsterker lar brukere trådløst koble ulike lydkilder til Rubens rør. Med to 100 W høyttalerutganger kan denne forsterkerenheten drive høyttaleren i Rubens rør og er tilstrekkelig også for mange andre høyttalere. Utgangene er standard høyttalertilkoblinger, som tillater bruk av 4 mm bananplugger, eller standard høyttalerledning. Kablet tilkobling til lydkilder støttes også via 3,5 mm Aux, og Micro USB-kontaktene på frontpanelet. Utgangsvolumet kan justeres ved hjelp av knappen på forsiden. Anbefalt strømforsyning: 18 V DC, 1 A (ikke inkludert)
Størrelse: 100 x 77 x 22 mm
• Vekt: 110g
Inngangsspenning: 9 til 24V DC
• Høyttalerklasse: 15 – 100W, 2 til 8 ohm
• Utgangseffekt: 2x 100W

Lyssensor, trådløs
Ta fem ulike lysmålinger med samme sensor i tillegg til RGB-verdi for fargen. Sensoren måler lysstyrke (lux), innstrålingstetthet (W/m2), UVA, UVB og UV-indeks i tillegg til å gi deg RGB.

Doppler-rakett
Solid dopplerrakett fra PASCO for en aktiv fysikkopplevelse! Lær om doppler effekten på en morsom måte! La to elever stå på hver sin side av klasserommet og la den kraftige doppler-raketten fyke fram og tilbake. Man vil tydelige høre det karakteristiske frekvensskiftet som blir tydelige til høyere hastighet raketten har. Forslag til anvendelse: Fly raketten horisontalt
Sving den over hodet
• Kast raketten som en ball




Fleksibane,125 cm
Fleksibanen er en fleksibel overflate laget av slitesterk PVC som måler 120 × 1220 × 3 mm med 5 mm sidevegger. Banen kan brukes til å lage buede eller skråplan for bruk med for eksempel biler. To baner kan kobles sammen ved hjelp av inkluderte plate og skruer, noe som gir ytterligere muligheter.

Apparat for sirkelbevegelse, Lascells
Konkretiser sirkelbevegelsen, slik vi lærer om den i skolefysikken med dette enkle og instruktive apparatet. Forsøket er både morsomt og enkelt å gjennomføre og dette klarer elevene fint selv. Et fjærsystem er innelukket i et akrylrør slik at man kan svinge en gummikule rundt i en horisontal sirkel for å måle sentripetalkraften. Radius og masse kan enkelt varieres og rotasjonshastigheten måles enkelt med ei stoppeklokke. Kreftene som virker kan måles i ”kraftinkrementer” eller i Newton hvis fjæren er kalibrert på forhånd. Instruksjoner er inkludert.

Fotocelle, dobbel med display
Med fotocellen fra japanske Narika måler du enkelt og presist farten til objekter uten å kjenne objektets størrelse. Farten leser du umiddelbart av i displayet i m/s, km/h eller cm/s. De fem siste målingene lagres. Med to fotoceller kan du i tillegg beregne akselerasjon, enkelt og med stor nøyaktighet. Drives av to LR03-batterier (inkludert).

Loop med kule på plate
Loop montert på plate inkludert to stålkuler (ulik diameter). Ytterst på banen er det montert en liten stoffpose til å fange opp kulen. I videregående skole kan man gjerne bruke loopentil å studere bevegelsen kvantitativt og regne på den minste farten kulen må ha for å klare loopen. Husk å ta hensyn til kulens rotasjonsenergi.
Spesifikasjoner:
Diameter loop: 20 cm
Baseplate: 40 x 10 cm med gummiføtter
• Kule: 2 stålkuler er inkludert

Newtons g-ball
Den originale G-ballen som har vært en favoritt blant naturfaglærere i flere tiår! Ballen er robust og inneholder en digital stoppklokke som kan måle tid mellom 0,01 og 29,99 sekunder. Den nullstilles ved å trykke inn knappen ved displayet. Tidtagingen starter når ballen slippes og stopper når ballen treffer underlaget. Da har man enkelt funnet falltiden og kjenner man høyden kan tyngdeakselerasjone bestemmes presist. Motsatt kan man bruke ballen til å bestemme f.eks. høyden til en person ved å finne falltiden for personens høyde, bruke tyngdeakselerasjonens verdi og regne ut høyden. Man kan kaste ballen rett opp og måle hvor høyt den kom, hva var hastigheten? Ballen er meget robust og klokken godt beskyttet. Den leveres inkludert batterier.

Med holderen på stang kan den doble fotocellen ved hjelp av standard stativutstyr enkelt monteres i enhver eksperimentoppstilling. Fotocellen settes på plass i holderen uten skruer og kan deretter plasseres akkurat i den vinkel og høyde man ønsker.

Badevekt med Newton-skala
Robust mekanisk vekt som veier opptil 125 kg/1250N. Fargen kan variere.


Bølgetank, elevmodell
Det kompakte brukervennlige bølgekaret fra Lascells leveres komplett med utskiftbare dyppere, barrierer, reflektor, refraksjonsplater, nettadapter og veiledning (engelsk). Kraftig LED stroboskop og synkroniseringsfunksjon kan gi deg frosset bilde (12 x 12 cm) eller du kan velge å la bølgene rulle fritt. La elevene selv eksperimentere med bølger og lære om refleksjon, diffraksjon, refraksjon og interferens.
2156,-



Funksjonsgenerator Basic
Enkel funksjonsgenerator for bølger og lyd. En enkel funksjonsgenerator, med kun to brytere for innstilling av frekvens og amplitude. Generatoren har store lettleste tall for avlesing av frekvensen. Bruk generatoren sammen med vibrator (107067) og annet tilleggsutstyr som fjær, gummisnor og pianotråd for å studere stående bølger, forskjellen på longitudinelle- og transverse bølger og mye annet. Kan også tilkobles høyttaler for å høre lyd ved ulike frekvenser.

Varenr.: Pris 102284 1495,-
Bølgekar Optika, komplett
Bølgekaret fra Optika er raskt å sette opp og består av et kammer for vann på toppen. En vibrator monteres på siden og ulike dyppere (enkel, dobbel eller lineær kant) påsettes denne. Deretter kan frekvensen på bølgene reguleres trinnløst og utleses om ønskelig. Kraftig stroboskoplampe (LED 3 W) sikrer tydelige bølgemønstre som fremkommer på mattglasskiva foran på karet. Stroboskopet synkroniseres med vibratoren (frosset bilde) eller styres manuelt. Inkludert er også pleksiglasslegemer for brytning. Bølgekaret leveres med fyldig og rikt illustrert veiledning
Typiske forsøk man kan gjøre med utstyret som er inkludert: Refleksjon og brytning
• Interferens
Sirkulære bølgefronter
• Planparallelle bølger danner sirkulære bølger

Vibrator LD
Meget god vibrator til svært gunstig pris. Kan brukes med de fleste funksjonsgeneratorer.



Tilbehør til vibrator
Med dette settet kan man undersøke ulike former for ressonans og hvordan den avhenger av frekvensen. Settet passer fint med alle våre funksjonsgeneratorer og vibrator 107067. Se vår hjemmeside for mer informasjon og bilder av forsøkene.
Innhold :
1 stk.kvadratisk Chladniplatte, side 16 cm.
1 stk sirkulær Chladniplatte, diameter 8 cm.
• 1 stk fjær, 75 viklinger, diameter 3 cm.
1 stk.pianoring, diameter 20 cm.
• 1 stk.bladfjær 13, 16 og 19 cm.
1 boks med blå sand.
• 1 stk. gummisnor



NÅ 723,-


//code.Node

PASCOs prisbelønte //code.Node er en kompakt, solid enhet for utallige kodeaktiviter! Den har fem kvalitetssensorer, spennende muligheter for output (RGB LED, frekvensstyrt høyttaler, 5 x 5 LED matrise) og to kontrollknapper . Elementene kan kombineres fritt og brukes i kodingen. I tillegg til blokkprogrammering i SPARKvue og Capstone er nå //code.Node en fullintergrert del av Python med sitt eget bibliotek!


//code Node, pk a 8 med holder
8 stk. //code.Nodes inkludert holder, ladekabel og bok med forslag til fine kodeaktiviteter.

//code.Node cart
//code.Node Cart er en solid bil hvor //code.Node passer i. Carten kjennetegnes av velkjent PASCO-kvalitet og meget lav hjulfriksjon. På bakre aksel sitter en magnet hvor magnetfeltet kan leses av //code.Nodes magnetfeltsensor. Dermer kan du også måle posisjon og fart. Carten har plass for ekstra lodd.


code.Node holder
Praktisk holder for //code.Node slik at den kan festes til ulike objekter. Monter den på armen eller en svingstol og sett opp morsomme kodeaktiviter med akselerasjonssensoren og ulike kode output!


micro:bit v2 (kun kort)
BBC micro:bit har blitt skole-Norges klart mest brukte microcontroller for koding i grunnskolen. Nå har den kommet med mikrofon, høyttaler og touchsensor som gir mange flere muligheter enn tidligere. Med BBC Micro:bit er det enkelt å finne mange spennende prosjekter for koding og programvaren er gratis. Her kan man begynne med blokkprogrammering og senere utvide til tekstbasert språk som Python og JavaScript.
Innebygget mikrofon
• Innebygget høyttaler
• Touch-sensor
Strømspare-modus

• 10 x BBC
10 x USB-kabler
• 10 x batteriholder
20 x AAA-batterier

Jordfuktighetssensor for micro:bit
• Spennings tilførsel: 3.3V or 5V
Utgangs signal: 0–4.2V
Strøm: 35mA
• Pinnekonfigurasjon: Analog utgang (Gul leder)
Jord (Sort leder)
Spenning (Rød leder)

LED-list for micro:bit
• Mål: LED-list 33 x 1 cm, totallengde 55 cm.
Driftsspenning: 3,0–5,5 V.
• Inn-/utgang: GVS-kontakter.

Nytt kompakt termokamera med Wifi og touchskjerm
Termokamera HIK Pocket2 er et batteridrevet (Li-ion – 4 timer) kompakt termokamera med touchskjerm. Kameraet måler temperaturer fra -20 °C til 400 °C med en nøyaktighet på opptil ±2 °C. HIKMICRO Pocket 2 er egentlig to kameraer i ett, du får både et bilde av varmestrålingen og et vanlig visuelt bilde og du kan kombinere det termiske bildet med det visuelle. Det gjør det mye enklere å analysere bildet som viser varmestrålingen. Kameraet egner seg godt både i industri og undervisning og bruksområdet spenner over alt fra å sjekke bygninger (oppvarming, ventilasjon, varmtvannsrør), maskiner og elektrisk arbeid til overføring av kinetisk energi til termisk energi eller undersøke kjemiske reaksjoner. Bildefrekvensen på 25 Hz gir mulighet til rask inspeksjon, og Wi-Fi-funksjonen lar Pocket2 dele bilder i sanntid. Pocket2 er et kraftig og lett termokamera som alltid er innen rekkevidde når du trenger det.
Spesifikasjoner:
16 GB flashminne med kapasitet for 30 000 bilder, 20 timer video
• 4 timer batterilevetid
NÅ 5525,Spar 15%
• Notatmuligheter på opptil 200 symboler per bilde. Kan kobles til HIKMICRO Viewer App via Wi-Fi eller hotspot for å overføre bilder til en mobiltelefon.
• Display: 3,5 ``
Mål/vekt: 138 x 85 x 24 mm / 220 g
• Inkludert er: Håndleddsrem, etui samt USB-kabel for lading og bildeoverføring

50° × 37.2° FOV (field of view) and 1.0 x to 4.0 x kontinuerlig digital zoom. Dette gir større flate med flere detaljer, uten ekstra fokusering.
Fluorescens system komplett RB
Varenr.: Pris
806005 6500,-


16 GB flashminne med kapasitet for 30 000 bilder, 20 timer video. Li-on batteri gir inntil 4 timers kontinuerlig drift.


Så lite og lett at det får plass i lomma. Inkludert er også softetui og håndleddsrem
Komplett system fra NightSea som påmonteres en vanlig stereolupe og muliggjør anvendelse av fluorescens. Utstyret kan brukes for alle prøver som fluorescerer og er perfekt for å undersøke prøver for mikroplast. Alt du trenger er inkludert i pakken og utstyret passer til nesten alle stereoluper (Bilde Motic SMZ-168, bruk gjerne en enklere modell) Vi presenterer her et komplett sett som sammen med en stereolupe inneholder det du trenger for å undersøke prøver for mikroplast eller andre prøver som fluorescerer. System inkluderer 6 deler
Nødvendig basisutstyr
• Lampefot med fleksibel svanehals og kontrollenhet
Nettadapter 120/240VAC, 50/60Hz
Enkel adaptering som passer til nesten alle typer stereoluper
Lys + filtersett:
LED-lys hode
• Filter (Royal Blue) som klikkfestes til adapteringen med magnet
Beskyttelsesglass laget av samme filtermateriale
NÅ 16602,Spar 10%
Bruk gjerne skolens stereolupe sammen med NightSea-utstyret. Er du i tvil, ta kontakt med oss. Hvis du behøver en ny stereolupe for dette formålet kan vi anbefale 307045 Stereolupe Fokus 10x, 20x, 40x

Se mikroplast i din stereolupe!

Varenr.: Pris
306060 18447,-